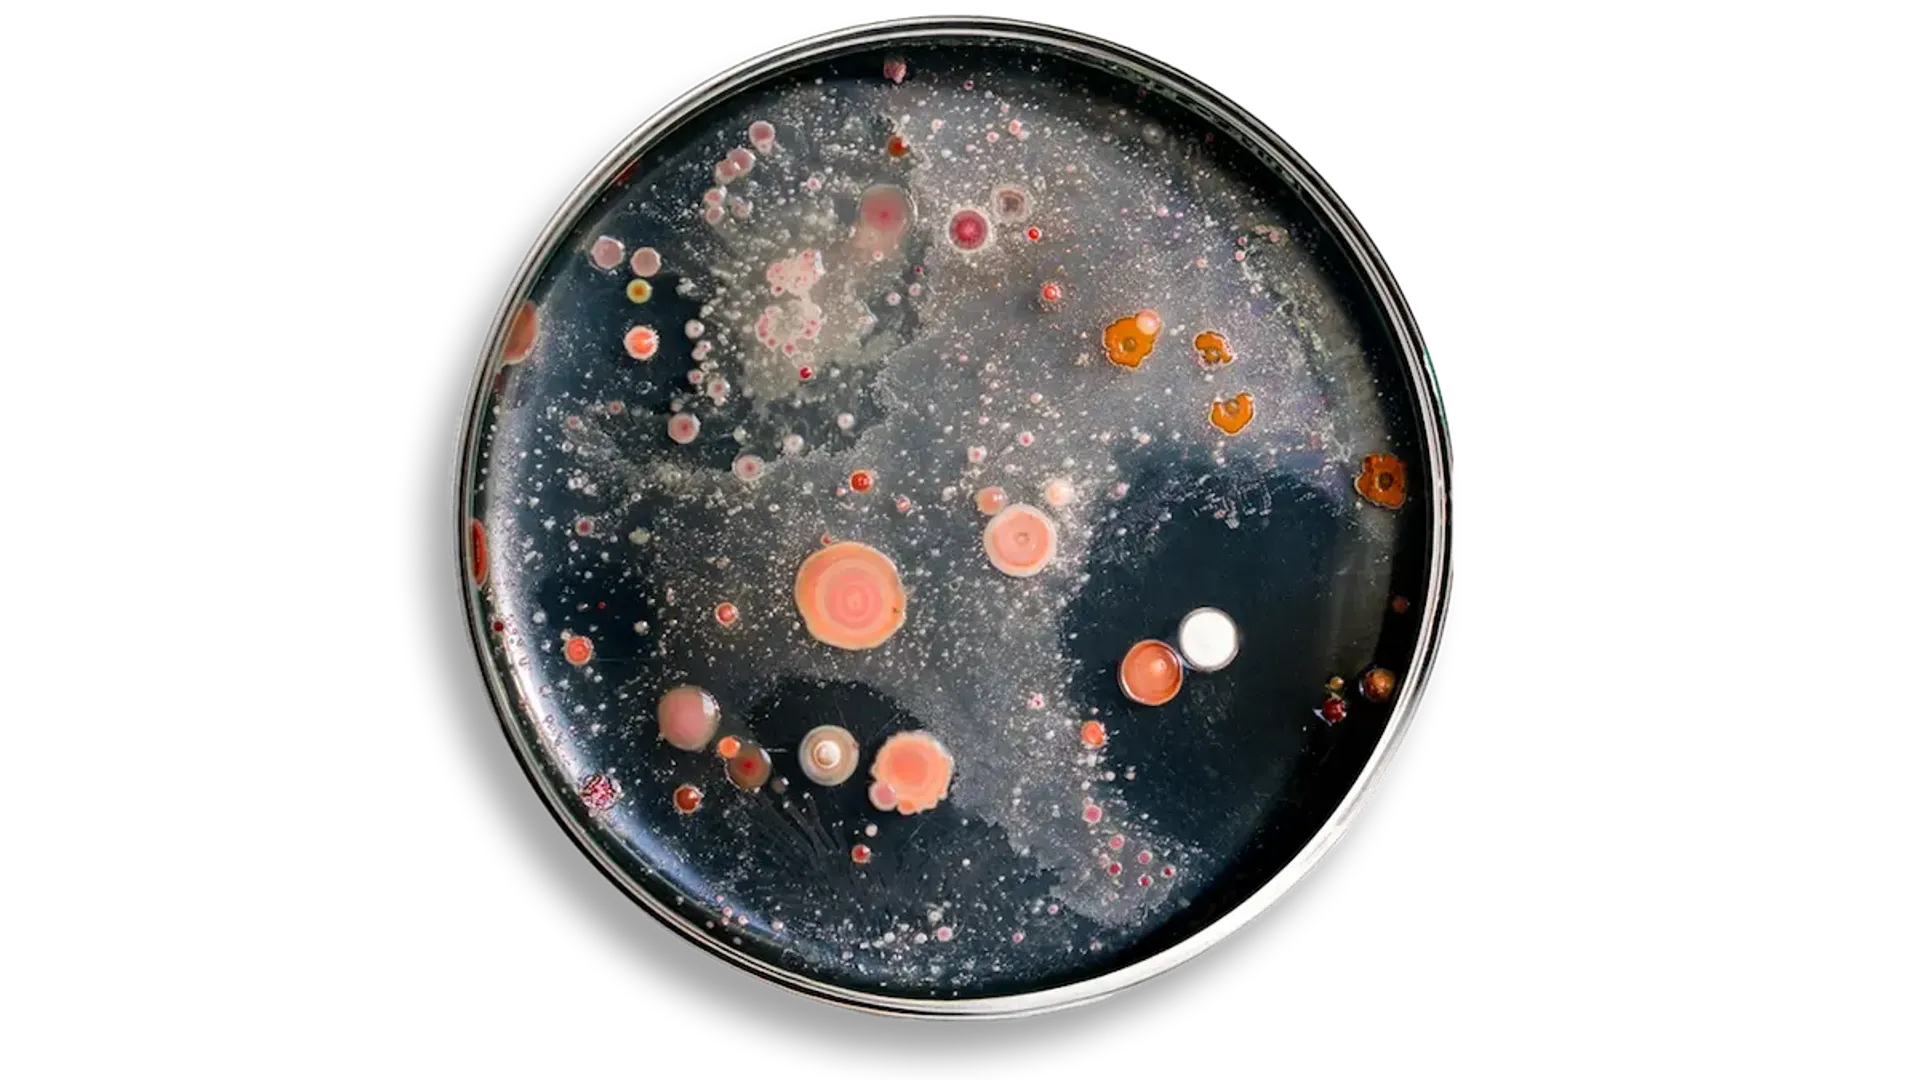
Biosolutions

Growth and Prosperity to 2035
The biosolutions sector is on the rise. This comprehensive report documents the momentum, showing how biosolutions drive job growth, competitiveness and economic resilience for countries across the globe.
What could biosolutions mean for your country?
The growing demand for innovative biosolutions could bring jobs, growth and resilience to your country. To seize the opportunity, policymakers, industry leaders, civil society and investors must work together – now – to create the right environment for biosolutions to reach their full potential.
Brazil
276,000 jobs and €877 (R$232.6) billion in growth are in store for Brazil by 2035 - if the right policies, investments and incentives are aligned. Get the whole story in the report.
Europe
Across 6 EU countries (Denmark, France, Germany, Italy, Spain, Poland) and the UK, biosolutions could drive more than 600,000 jobs and €133 billion in economic gains in the next decade. See the breakdown.
Denmark
In Denmark alone, biosolutions could generate 40,900 jobs and up to €12.9 billion in output value by 2035. Find out how to help realize the opportunity.
Australia
China
Colombia
India
Indonesia
Japan
Mexico
South Korea
Turkey
What are biosolutions?
Microbes, enzymes, and other proteins are the building blocks of all living things. Using modern science and technology, these microscopic changemakers can be used as solutions to help businesses reduce waste, save energy and water, cut dependence on fossil resources, and develop innovative and profitable products.
These biological solutions – ‘biosolutions’ – are already used across more than 30 industries from preventive health and industrial applications to agriculture and food production. They represent a growing transformation that promises to reshape economies and accelerate the transition towards a sustainable, resilient and competitive future.

5 million jobs globally
At a time of disruption for many global industries, people everywhere are feeling insecure about their livelihoods.
With the biosolutions sector expected to grow significantly by 2035, 5 million jobs will be generated globally. Discover the opportunity for your country.

€877 billion in growth
Biosolutions are addressing some of the world’s most pressing challenges and transforming economies along the way.
With the right policies and investments in place, €877 billion could be generated by biosolutions output globally. Find out what it could mean for your communities.

Lasting economic resilience
Real economic resilience relies on sustainable investments and robust policy frameworks.
Your country could be in a unique position to leverage the significant promise of biosolutions. Discover how to lay the groundwork in your country.
Why explore the report?
Produced by Amsterdam Data Collective (ADC), this first-of-its-kind report quantifies the economic impact of the biosolutions sector globally and in specific countries.
It provides policymakers with the data and analysis they need to make informed decisions to unleash the potential of the biosolutions sector and deliver on jobs, economic growth, energy diversification and food security in their countries.
- It includes:
- • A consistent definition of biosolutions to ensure comparable accurate data and analysis across countries.
- • A comprehensive assessment of the current and future economic footprint of biosolutions.
- • Actionable policy recommendations that allow the biosolutions sector to thrive well into the future.









